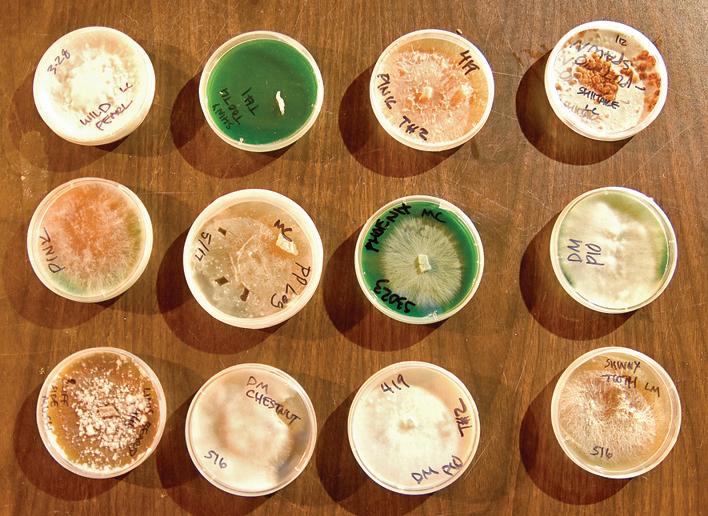

hIstory Hot dısh WITH
















Dodge County Free Fair keeps to its local roots

 BY AMY KYLLO | STAFF WRITER
BY AMY KYLLO | STAFF WRITER





KASSON – Minnesota has always known that a hot, full course meal in a 9-by-13 cake pan is called a hot dish rather than a casserole. As such, it is fitting the oldest county fair in the state of Minnesota has a hot dish competition.
The Dodge County Free Fair, which is celebrating its 166th year, will be having
a hot dish competition during the fair July 12-16.
The hot dish competition is a newcomer to the historic fair, with this being its fourth year. Kelly Caspers, a fair board member, helped start the competition.
“We thought, well, what better ... than hot dish because that’s a Minnesota thing,” she said.
The hot dish creations have to follow certain ingredient rules. This year, they must have a barbecue protein,
vegetable(s), dairy or canned soup, and a starch.
“We twist the hot dish up,” Caspers said. “There always has to be something fair related.”





Last year’s champion was long time Dodge County employee, Lisa Kramer.
She made a bacon cheeseburger hot dish with fried pickles and topped it with onions to take home the top prize.

“It’s just fun,” Kramer said. “I like to cook. I like competition. ... So, I’d like to edge out anybody else.”

Kramer also participated in the pie competition. When deciding what to make, Kramer keeps her audience in mind to match recipes and flavors with the generation who will be judging them.
Caspers said the fair hopes to publish a cookbook with pie and hot dish recipes after a few years of both competitions.





The Dodge County Free Fair has multiple attractions at the grandstand fairgoers can enjoy like bull riding, stock car racing, a demolition derby, trailer racing and, new this year, autocross races.





Trailer racing, which started a few years ago, has quickly gained popularity at

the fair. Vehicles pulling trailers race while trying to unhitch the trailers of competitors. Participants can purposely ram the trailers but cannot ram the vehicles. The result is entertaining chaos.
Marilyn Lermon, who has been on the Dodge County Fair Board for 28 years, has seen how the community has gained affinity for the trailer races.


“They all come out to watch their friends,” Lermon said. “It









gets to be just a hilarious event.” Adding to the fun is the fact the participants decorate their vehicle and trailer entries as well.
When adding events and planning, Caspers said the fair board is focused on keeping the fair rooted locally. She said they do not want to be flashy but instead aim to keep the fair focused on the basics.
Dodge County, welcome to Country Acres South!
Read about local fairs, agriculture and hidden gems in your area!



Saturday, July 1, 2023 | Country Acres South • Page 1 Saturday, July 1, 2023Volume 2, Edition 3 Focusing on Today’s Rural Environment ST R Publications bli ti The newspaper of today is the history of tomorrow. Watch for the next edition of Country Acres on July 15, 2023 SOUTH PRSRT STD ECR U.S. POSTAGE PAID PERMIT #278 Madelia, MN 522 Sinclair Lewis Ave Sauk Centre MN 56378
PHOTOS BY AMY KYLLO
(Above Left) Lisa Kramer smiles with her grand champion ribbon and engraved glass baking dish from hot dish competition at the 2022 Dodge County Free Fair in Kasson. The fair board hopes to eventually make a cookbook using recipes from the hot dish and pie competitions.
(Above Main) People gather in the grandstands during the 2022 Dodge County Free Fair in Kasson. The grandstand entertainment includes bull riding, trailer racing, a demolition derby and autocross racing.
1, 2023 3 S
Ribbons hang from canned goods at the 2022 Dodge County Free Fair in Kasson. The fair board focuses on keeping the fair local and true to its roots.
Dodge County page 2 4 Core summer memories Amy Kyllo column 5 Fillmore County Fair Preston 7 Dodge County Fair Kasson 8 Fungi furthers a movement Rochester 9 Wabasha County Fair Wabasha 12 Winona County Fair St. Charles 13 A journey of service, faith Byron Country: This month in the
Lisa Kramer's champion bacon cheeseburger hotdish. Kramer prepared this hotdish for the 2022 Dodge County Free Fair.
SOUTH
Published by Star Publications












Copyright 2023



522 Sinclair Lewis Ave. Sauk Centre, MN 56378
Phone: 320-352-6577 | Fax: 320-352-5647
NEWS STAFF
Sarah Colburn, Editor, sarah.c@star-pub.com
Amy Kyllo, Assistant Editor, amy.k@star-pub.com
Mark Klaphake, Writer, mark.k@dairystar.com


Tiffany Klaphake, Writer, tiffany.k@dairystar.com
Jan Lefebvre, Writer, jan.l@star-pub.com
Ben Sonnek, Writer, ben.s@saukherald.com
Hans Lammeman, Writer, hans.l@star-pub.com
Alex Christen, Intern
Story ideas send to: sarah.c@star-pub.com

SALES STAFF
Laura Seljan, 507-350-2217, laura.s@dairystar.com
Julia Mullenbach, 507-438-7739, julia.m@star-pub.com

Missy Traeger, 320-291-9899, missy@saukherald.com
Tim Vos, 320-492-6987, tim.v@star-pub.com
Mike Schafer, 320-894-7825, mike.s@dairystar.com







Warren Stone, 320-249-9182, warren@star-pub.com
Jaime Ostendorf, 320-309-1988, jaime@star-pub.com
Bob Leukam, 320-260-1248, bob.l@star-pub.com


Neil Maidl, 320-292-4454, neil.m@star-pub.com
PRODUCTION STAFF
Amanda Thooft | Nancy Powell | Maddy Peterson
Cheyenne Carlson | Karen Knoblach | Annika Gunderson
ISSN Print: 2834-6491 | Online: 2834-6505
Deadlines:
Country Acres will be published the first and third Saturday of every month. Deadline for news and advertising is the Thursday before publication.


ST RPublications bli ti
“Committed to being the eyes and ears of our communities.”
Dodge County from front
“We really want to instill things that are from our county,” Caspers said. “We really try to amplify that to (say) this is who we are.”
As a county with a continued rich agriculture presence, supporting 4-H and FFA is a big part of the fair.
Kristen Heeren is a long-time participant in the Dodge County Free Fair. Her parents, Carl and Rhonda Weis, who met through 4-H, both showed animals and passed it on to Heeren and her siblings and now grandchildren.

Heeren appreciates the life lessons her children acquire through showing animals at the fair.
“My husband and I really want our daughters to be able to understand
Kids
Fair in Kasson.

fair’s
dairy farms thanks in part to a strong lease




the husbandry of taking care of animals,” Heeren said. “You treat an animal right, it’s going to treat you right just like if you treat people right, they’re going to treat you right.”
For Heeren, the local fair has created a deep sense of community.
Dodge Dr. Square Foot auctions will show you lots of homes, buildings, land by ACRE - YARD - !
page Real Estate Auctions Certified Appraisals

“The Dodge County
all phenomenal about trying to make sure our kids are successful.” Ron Sheridan, Dr. Square Foot Auctioneer #25-33 | Certified Appraiser #08404 www.drsquarefoot.com | 651-246-4146 | Rochester & Zumbrota
Page 2 • Country Acres South | Saturday, July 1, 2023
PHOTOS BY AMY KYLLO
show dairy cattle at the open class junior show at the 2022 Dodge County Free
The
animal shows have remained strong in spite of decreasing
program.
Debris flies through the air at the trailer race grandstand event at the 2022 Dodge County Free Fair in Kasson. Vehicles pulling trailers race while trying to unhitch the trailers of competitors.
Great Used Equipment Deals all Around! Check out www.dankersent.com for more used machinery | Call and ask for Bruce Check out our full inventory! FINANCING AVAILABLE CASE IH FHX300 Pull-type Forage Harvester $42,000 CASE IH FHX300 Pull-type Forage Harvester $30,000 CASE IH FHX300 Pull-type Forage Harvester $27,500 BADGER 1200 Forage Wagons Harvest Equipment $8,500 H&S FBXC7419 Forage Wagons Harvest Equipment $23,000 H&S FBXC7419 Forage Wagons Harvest Equipment $23,000 2006 MEYER 4516 Forage Wagons Harvest Equipment $12,500 MILLER PRO 5200 Forage Wagons Harvest Equipment $13,500 MEYER TSS Forage Wagons Harvest Equipment $7,500 www.dankersent.com 4960 Moundview Drive | Red Wing, MN 55066 | (651) 327-2627 CZJuly1-1B-BL 4 9
County
Fair is kind of like family,” she said. “It’s a such a great small community. Everybody works super hard, and the parents are 3 CZJuly1-1B-JM





















































Core summer memories
This summer I’ve been especially aware that we have reached the critical three months of the year that I live for the other nine months in Minnesota to experience, also known as summer.
The Fourth of July has always been a good day of the summer. Growing up, I remember we rotated every other year on our celebrations between a family gathering that had a swimming pool and going to Wanamingo to their parade.
 Sunshine & Flowers by Amy Kyllo
Sunshine & Flowers by Amy Kyllo

Before and after the parade we would gather at Grandpa and Grandma Kyllo’s in Wanamingo. I remember Grandma offering seconds on ice cream and, like a smart kid, I took her up on it.
We never really went to firework shows because they always landed over, or too close to, evening chores. Yet, then again, we didn’t really need to. I remember standing out in the pasture feeding calves in the warm darkness or standing in the yard and watching bits and pieces of fireworks displays that reached our farm.
On normal days without fireworks, the evenings would still light up with a simpler display. Hundreds of fireflies would twinkle through the night like an Owl City song.







As I grew older on the farm, I always had a love hate relationship with summer. On one hand the weather was great and on the other hand the workload during summer was a lot between the calves and field work.
To me summer meant haylage. Lots of it. It seemed that by the time we put up first crop, then new seeding alfalfa overseeded with oats and peas, and then Sorghum Sudan, it was time for second crop hay.
Buzzing up and down the road in the tractor with the chopper box behind and the radio blasting in my ear muffs, and sitting in the tractor unloading into the bagger, made up many of my summer days.




My radio earmuffs would switch between KROC AM 1340 for the Twins games and the Dave Ramsey show and 98.5 KTIS and 92.9 for Christian contemporary music.

I’m not a naturally good driver or mechanically minded, but I’m so glad that my dad was persistent and insistent that I learn how to drive tractor. Over countless summer hours I became able to fill the role adequately.




Nowadays, everyone likes to talk about having a “Hot girl summer.” I sure had them if it counts as having fresh sweat on top of dried sweat, remains of old sunscreen protecting my 1800s era skin tone from cancer, bits of haylage and dust clinging to everything, grease from hooking up the PTO shafts on my arms and hands and some dried colostrum from morning calf feeding on my jean shorts. You can always tell the difference in moisture on the haylage by how many hay bits are sticking to your skin.





When we were chopping, we had lots of picnic suppers. The family would gather out in the hayfield and sit against a wagon tire or wherever with a sandwich, fruit, juice and some kind of “sweet tooth,” also known as dessert, in hand.
I don’t think we always realize it when we’re making memories. We had so many picnics like that each summer I couldn’t even count them. They were just solid, everyday memories that shaped my life.
If we were super busy, Mom would make us each an individual ice cream bucket with our lunch in it. The lunches were always delicious, but the trick always became finding a way to eat them between and while operating a tractor, chopper box and bagger safely. If someone was running a little behind and you had to wait was the best because you didn’t have to try to eat and pay attention all at the same time.
Crazy how times change. I write this at the kitchen counter of an air-conditioned apartment. My days look drastically different than they did just a few summers ago yet I’m grateful for each of those days filled with everyday memories. As you look at the summer in front of you, I hope you realize the memories you’re making and stop in the hard, dirty moments to realize that for good and bad, those days don’t last forever.
Page 4 • Country Acres South | Saturday, July 1, 2023 mmcjd.com Savings good through July 31, 2023. Financing options available with approved credit through John Deere Financial. Some restrictions apply; see your local Midwest Machinery for details. Prices and monthly payments include installation and setup, but do not include sales tax. Payments based off of a $0 down payment. Financing offers may require a financing fee. $ 1,000 OFF 0% FINANCING AVAILABLE 1025R COMPACT TRACTOR LOADER & TILLER PACKAGE $ 0 DOWN 0% FOR 72 MONTHS Payment $360/mo 835M GATOR w/HVAC CAB (Heat & AC) $ 0 DOWN 3.9% FOR 84 MONTHS* Payment $415/mo CZJuly1-1B-BL
Used Engines • Used Transmissions • Used Cabs • Used Rear Axel www.LKQHEAVYTRUCK.com Thompson Motors | Wykoff, MN 1-800-862-2002 CZJune17-1B-JM 2005 INTERNATIONAL 9200 Stk# 180551-869 - $22,950 2013 Kenworth T600 Stk# 180445-869 - $34,950 2005 International Transtar 8600 Stk# 178262-869 - $22,950 CUMMINS CUMMINS 2001 International 9100 Stk# 181385-869 - $18,950 CUMMINS CUMMINS Over-Time Optional | Experience Preferred | Willing to Train Please email resume to merrileasmith@gmail.com (651) 345-3990 | 1705 N OAK STREET, LAKE CITY, MN N O W H I R I N G A F U L L T I M E CZJul y 1-1B-TV
MARINE MECHANIC
SMITTY’S MARINE































































a movement





Quality, community development at core of Frozen Cap Mushroom Farm


 BY AMY KYLLO | STAFF WRITER
BY AMY KYLLO | STAFF WRITER






















ROCHESTER – From the outside, no one would ever know thatin the unfinished basement of one very ordinary Olmsted County home is an entire farm. In the basement, shelves hold clear plastic bags of what appear to be molding grain.









y OeCo y oeee.eee,eeoe p gs o ppeo e grain be





In a space around the corner created by the stairwell, two tall, box-like grow tents hold the real sorcery of this cent, substantial yet delicate mushroom forests
In a space around the corner created the two box-like grow tents hold the real sorcery of this Inaspacearoundthecornercreatedbythestairwelltwotallboxlikegrowtentsholdtherealsorceryofthis unusual farm. A zipper doorway fully reveals shelves with magnificent, delicate mushroom forests in miniature growing from the sides of grow blocks like a modern-day fairytale.
Jeremy Herdrich owns Frozen Cap Mushroom Farm. He markets his mushrooms at two farmers markets in Rochester and sells to local chefs at restaurants such as CRAVE American Kitchen and Sushi Bar and Forager Brewery in Rochester.


and to

Frozen Cap Mushroom Farm began 2.5 years ago as a hobby.

Fung n i page 10


Jeremy Herdrich smiles June 5 inside one of his grow tents in the basement of his home in Rochester. Herdrich started growing mushrooms two and half years ago as a hobby and has seen his hobby grow into a business.

Page 8 • Country Acres South | Saturday, July 1, 2023 023 Page8 • CountryAcresSouth |Saturday,July1,20 8 Acres South Saturday, July 1, 20
PHOTO BY AMY KYLLO
32ND ANNUAL Hastings, Minnesota • July 28–30, 2023 See the Original Porky’s Drive–In Diner! Saturday Tractor & Truck Pull See our full schedule of events! $12 Adults • $24 Weekend Pass • 12 & Under FREE Show Hours: 8 am - 5pm www.littleloghouseshow.com | info@littleloghouseshow.com | 651-437-2693 • Old West & Military Reenactments • Living History Demonstrations • Food & Beverages • Parade • Pancake Breakfast • Flower Gardens • Flea Market & Crafts • Children’s Barnyard • Live Music....much more! ANTIQUE POWER SHOW Step back in time and history... Featuring: Little Log House S O P D Tour 50+ BUILDINGS CZJuly1-1B-BL































































































































When Herdrich began getting phone calls for mushrooms from people who were not family or friends, he started to realize he had a business.

Originally a native of Fayetteville, Arkansas, in the Ozark Mountains, Herdrich has an entrepreneurial spirit. He can give a recommendation for the best salon products for curly hair, grow micro greens, do construction demolition, grow mushrooms, work with urban development and more.



Herdrich’s mission is a higher standard of mushroom farming, a standard that focuses on quality over merely harvesting a certain number of pounds of mushrooms.









Herdrich’s inspiration is his community. He especially focuses on equipping others to be able to grow their own food.
“I do this for my family; I do it for my community,” he said. “It’s a movement that’s bigger than me. It’s a movement that’s bigger than my community. It’s infectious.”
Herdrich runs his mushroom business solo and hopes to be able to
Good jobs right here, right

do a large expansion in the near future in collaboration with another area farm. He plans to increase his workforce with veterans. Herdrich himself is a veteran of the U.S. Marine Corps.




“I want to be able to provide a potential foundation or a point of contact for these people that could be going through a hard transition,” he said. “Be able to provide them something that may feed their soul and maybe find a sense of ease.”

Herdrich sources his mushroom grow materials, such as his grow blocks, locally. Spent mushroom blocks are sent to a local farm, community gardens or are free for people to pick up to be used as fertilizer, mulch or to grow more mushrooms.

Local is what Herdrich supports and the way he lives his life.

“Your voice matters the most at the local level,” he said. “A lot of our food is being shipped from

















thousands of miles away, and it’s harvested not in its prime and it’s not supporting the community.”

Herdrich has a library of 65 mushrooms cultures. He keeps this library as back up in case he loses a strain. Usually, Herdrich repropagates mushrooms from past mushrooms.
“Once you have one mushroom, you have mushrooms for the rest of your life if you follow the














Page 10 • Country Acres South | Saturday, July 1, 2023
now! Crest has openings for: C R E S T P R E C A S T Crest will train you for any of the listed positions and pay you a decent living wage. If you are willing to work, and want to learn, this is the perfect team to join as the precast industry is a growing career opportunity! • Manufacturing positions (includes assembling forms, rebar placement & pouring concrete) • Delivery position (for swing boom crane in safe modern equipment, CDL required) • Ready Mix Driver (Class A or B license) joan@crestprecastconcrete.com amber@crestprecastconcrete.com Call 1.800.658.9045 or Text 608.769.4005 Steve CZJuly1-1B-JM 609 Kistler Drive, La Crescent, MN 55947 Dynamic Masonry Products LLC www.dynamicmasonryproducts.com STONE | BRICK | BLOCK & LANDSCAPING SUPPLIES Jordan Steier 507-315-1000 jordan@dynamicmasonryproducts.com 609 Barbaree Lane | Byron, MN 55920 CZJuly1-1B-JM Serving your recreational sales and service for over 50 years! We specialize in servicing Johnson, Evinrude & Suzuki motors. We have new pontoon trailers in stock. We do boat motor repowers! (651) 345-3990 | 1705 N OAK STREET, LAKE CITY, MN CZJul y 1-1B-TV SMITTY’S MARINE 14”-32” Bars on hand Chainsaws 507.534.2431 665 N Wabasha | Plainview www.pierceoutdoorequipment.com SALES AND SERVICE SINCE 1950 | 507.534.2431 CZJuly1-1B-TV SCHEDULE YOUR MAINTENANCE TODAY!
Fungi from page 8
PHOTOS BY AMY KYLLO
(Above) Black Pearl oyster mushrooms grow June 5 in a grow tent at Jeremy Herdrich’s home in Rochester. Because all his mushrooms are hardwood decomposers, they are growing on blocks that are 50% wood pellets and 50% soy hulls.
(Left) Jeremy Herdrich holds a jar of liquid mushroom culture up to the light June 5 in his home in Rochester. Herdrich taught himself to grow mushrooms.
45 3rd St. NW, Plainview, MN 55964 www.highplainscoop.com CZJuly1-1B-TV Give us a call It’s a great time to switch to a new propane company. If you’re in the market for a propane company that is not corporate owned, give us a call at 507-534-3111 507-534-3111 800-927-4256 SUMMER’S Here! Stinson’s Country Style Meats Mon - Fri: 9 am - 6 pm | Sat: 8 am - Noon | 402 W Cedar St, Houston, MN 507-896-2111 | www.stinsonscountrystylemeats.com We provide processing for beef, pork, lamb and venison! We have the perfect meat for your summer grill out! GRILLING season it’s CZJuly1-1B-JM Lewiston 225 East Main St. Lewiston, MN 55952 Wykoff 102 Gold St. N Wykoff, MN 55990 Spring Valley 640 N Broadway Ave Spring Valley, MN 55975 CZJuly1-1B-JM
Fungi page 11
process correctly,” he said.
Herdrich raises his mushrooms seasonally with warm-loving mushrooms growing in the summer and cold-loving mushrooms growing in the winter for a total of about 15 varieties.
“It’s easier to work with the mushrooms than it is trying to force them into something that they don’t need to necessarily do,” he said.
Most of the mushrooms are different types of oysters, but Herdrich also grows varieties like Lion’s mane as well as a selection of medicinal mushrooms.
Effective mushroom growing takes the control of four variables: temperature, humidity, light and oxygen exposure.
Herdrich uses a fourstep grow process. He starts with agar in a Petri dish inoculated with mushroom spores. Once the agar dish has been propagated, he moves the growing inoculation to a small, sealed bag of grain. He uses a combination of 70% oats to 30% millet in the bags.
As the mycelium begins to grow in the grain bag, Herdrich transfers it to a larger bag of grain. In the final step, he transfers a portion of the grain to a fruiting block bag. The
fruiting block is made up of 50% hardwood pellets and 50% soyhulls. All the transfers are done with a laminar flow hood to provide sterilized air so he can do the transfers in the open air.
The mushrooms Herdrich grows are all hardwood decomposers. The fruiting blocks are placed in a grow tent where the mushrooms fruit out. The full process from Petri dish to fruiting takes about two months.
Herdrich sells the harvested mushrooms fresh or freeze dries them. Herdrich said he likes freeze drying because the finished product can be broken into a powder which is useful in making sauce.

Herdrich taught himself how to grow mushrooms.
“I was blessed by my father with this annoying gene of curiosity,” he said. “I’d find out who the best of the best of the best was, and I would reach out to them.”
Mushrooms can be grown in many ways, but Herdrich has opted for a labor-intensive, focused, controlled variables path to growing mushrooms in polypropylene bags.
“The method that … (I’m) getting close to mastering … is the high cultivation, quick turn and burn,” he said.
Herdrich said he hopes his operation will be at a




Jeremy Herdrich uses Petri dishes to check for spore contamination. The dishes rest on a table June 5 in the basement of his home in Rochester. Herdrich uses a laminar flow hood to provide sterilized air so he can do grow transfers in the open air. place where it can self-sustain.

“I want my company to be (a) common asset,” he said.


Someday, Herdrich said he hopes Frozen Cap Mushroom Farm can provide for the community around him.


“I see Frozen Cap
Mushroom Farm eventually being able to purchase a substantial amount of land and be able to have gardens available for people,” he said. “Maybe a healing center for people that are again just coming out of the military. Who knows, it’s pretty much limitless.”

Saturday, July 1, 2023 | Country Acres South • Page 11 (651) 345-4224 401 S 8th St, Lake City, MN 55041 FOR ALL YOUR ROLL OFF & GARBAGE NEEDS! CZJuly1-1B-TV Recycling & Disposal Lake City 38817 County Road 3, Lake City, MN 55041 507-753-2408 507-273-1999 CZJuly1-1B-TV – We install lift pumps – Opening sewer lines – Tank finder LAKE CITY, MN MANTHEI Septic Service The Best in Animal Care for 54 Years Large & Small Animal Medicine & Surgery Harmony 507-886-6321 Cresco 563-547-3121 Drs. Rein, Collins, Remold, Sadler, Hanson CZTFN_1B_JM
Fungi from page 10
PHOTOS BY AMY KYLLO
TOM HEFFERNAN Celebrating 50 Years! Low Overhead on New & Used Cars & Trucks WE PAY TOP DOLLAR FOR USED CARS See our inventory: TomHeffernanFord.com 651-345-5313 310 N L AKESHORE DRIVE | LAKE CITY, MN CZJuly1-1B-TV AUCTIONEERS: Andrew Hamilton, Bill Hilton; Sales Associates: Jeff Thorsen, Bob Grass; CLERK: Hamilton Auction Co. 130 State Hwy. 16, Dexter, MN 55926 (507) 584-0133 WWW.HAMILTONAUCTIONCOMPANY.COM SELLING AGRICULTURE LAND, FARM & CONSTRUCTION ASSETS CZJuly1-1B-JM More dates to be added as the year goes on! * Taking Consignments Now! Please call the office 507-584-0133 Al & JoAnn Everman Farm Retirement Auction (Online Only) Pre-Harvest Consignment Auction* (Online Only) Marchant Motors Retirement Auction (Online Only) NY Industrial & AGT Attachment Auction (Online Only) Randy & Kris Hamilton Farm Retirement Auction (Online only) Al & Lori Stier Farm Retirement Auction (Live & Online) Ken Folie Estate Auction (Online Only) After Harvest Consignment Auction (Online Only) 2-Day Annual Labor Day Auction (Live & Online) 2023 Upcoming Auction Schedule 2023 Sun. & Mon., Sept. 3 & 4 Wed., Sept. 27 Tues., Aug. 1 Wed., Sept. 20 Thurs., July 13 Thurs., July 20 Sat., Dec. 9 Thurs., Aug. 10 Tues., Dec.12 CZJuly1-1B-JM
165th Winona County Fair • July 12 to 16, 2023






























This page is brought to you by these businesses: For more information, visit: www.winonacountyfair.com





Page 12 • Country Acres South | Saturday, July 1, 2023
Years in St. Charles, MN Come Wednesday July 12 Steve Jacob Day 4 pm Flag Raising Ceremony Livestock Judging 12 pm All open class & 4-H livestock and rabbits to be in place 2 pm 4-H Horse Judging- Games Horse Arena 6 pm 4-H Dairy Judging Contest 6:30 pm 4-H Swine Show-small arena Entertainment Tent 7 pm Square Dancing (Kaleidoscope Squares) Thursday, July 13 Vernon & Linda Thill Day Livestock Judging 8 am 4-H Beef Show-Large Arena 8:30 am 4-H Dairy Goat Judging-Small Arena 1 pm 4-H Dairy Steer Show-Large Arena 3 pm 4-H Goat Judging-Small Arena 6 pm 4-H Lamb Lead & Fleece-West side of Large Arena 6:15 pm 4-H Sheep Show-Large Arena Entertainment Tent 9 am Winona County Soil and Water Conservation District Meeting 2 pm Recognition Program 6 pm Music by Brad Boice Elvis & Classics 2-hour show 8:15 pm Music by Eric Ebert Wisconsin’s Favorite Neil Diamond Tribute Artist 2-hour show Other Activities 12 pm - 5 pm Chair Caning-Wanda Hanson 12:30 pm Antique Tractor Parade 1 pm - 5 pm Rock Painting-Lisa Douglas 4 pm - 9 pm Bingo 6 pm Classic Tractor Pull Friday, July 14 Jon Arnold Day Livestock Judging 8:30 am 4-H Dairy Cattle Show 9 am 4-H Poultry Show followed by Open Class Poultry Show 1:00 pm 4-H Rabbit Show followed by Open Class Rabbit Show Small Arena Entertainment Tent 10 am Daycare Day (Pre-registration required) 4 pm Pedal Pull 7 pm Music by Gate City Jazz Band Other Activities 12 pm - 5 pm Chair Caning-Wanda Hanson 1 pm - 5 pm Zentangle Demo 6 pm - 7:30 pm Intro Zetangle Class-Lisa Douglas 2 pm - 9 pm Bingo 7 pm Tri-State Truck & Tractor Pull Saturday, July 15 Clifford Pierce Day Livestock Judging
am Winona County Market Livestock Auction-Small Arena 1:30 pm Open Class Beef Cattle Show-Large Arena 5 pm Open Class Sheep Trailer ShowLarge Arena Entertainment Tent 10 am Horseshoes at Moose Club 11 am Spinning/Weaving Demo Lisa Douglas 12 pm Lego Building Contest (Bring your own Legos) 1:30 pm Charcuterie Board Contest 2 pm Fastest Fingers in the West for Knitters and Crocheters 2:30 pm FROZEN T-Shirt Contest 3 pm Vegetable Carving Demo-Jie Schloegel 4 pm Music by GrassRun Band 7 pm Open Class Talent Show Other Activities 12 pm- 4 pm Doug Ohman-Story Teller & Photographer Heart of the Farm-Barns of MN | 12 pm The County Fair | 2 pm Golden Age of Agriculture | 4 pm 2 pm - 9 pm Bingo 5 pm Trailer Races
July 16 Rita Baer Day Livestock Judging 1 pm All Species Showmanship-Large Arena 2:40 pm 4-H Parade of Championship-Large Arena 4 pm 4-H and Open Class Livestock Released 6 pm 4-H Non-Livestock Exhibits Released 7 pm Open Class Non-Livestock Exhibits Released Entertainment Tent 9 am - 12 pm Pancake Breakfast by: St. Charles Lions Club 10:30 am Ecumenical Service hosted by: First Presbyterian Church 12:30 pm Music by The Bandanas 2 pm Music by Ravens Fire Band-Irish, Folk & Americana Other Activities 12 pm - 2 pm Oil/Pastel Demo-Jamie Schwaba 12 pm - 5 pm Bingo 5 pm Trailer Races
113
9
Sunday,
Heger Ins and Fin Svc Inc
Heger, Agent 1024
Saint
joinus Dana
Dana
Whitewater Avenue
Charles, MN 55972-1133
ROLLINGSTONE 111 Elm St., Rollingstone, MN 55969 507-689-2125 Business Hours: Monday - Friday: 6:30 AM - 5:00 PM Saturday: By Appointment Only Sunday: Closed WINONA 115 Franklin St., Winona, MN 55987 507-454-3120 Business Hours: Monday - Friday: 6:30 AM - 5:00 PM Saturday: By Appointment Only Sunday: Closed We are a full service lumber yard serving all of your building needs. www.kendelllumber.com The Answer Store Ph: (507) 689-2121 103 Main Street, PO Box 66 Rollingstone, MN 55969 1230 S. Main St. • Elba, MN 507-796-6571 • 507-932-3861 SINCE 1902 COOPERATIVE AG SPECIALISTS “QUALITY, SERVICE AND EXPERIENCE.” 1361 Whitewater Ave. St. Charles, MN Your feed specialistsfeaturing Big Gain Feeds 507-932-4800 Stinson’s Country Style Meats 507-896-2111 | 402 W Cedar St, Houston, MN Mon - Fri: 9 am - 6 pm | Sat: 8 am - Noon JOIN LSP FOR UPCOMING PASTURE WALK EVENTS Learn more at landstewardshipproject.org/2023-pasture-walks/ Nikki & Cody Meyer (Dorchester, IA) - July 13 Rachelle & Jordan Meyer (Caledonia, MN) - August 5 On-Farm Discussion: Custom Grazing Dairy/Beef Heifers (Rushford, MN) - August 19 Nathan Vergin (St Charles, MN) - September 21 Jeremy Holst (Lake City, MN) - October 19 Alan Bedtka (Dover, MN) - November 1 Midwest Equipment 976 West 12th | St. Charles, MN 55972 (507) 932-4464 ext. 2 H A V E F U N A T T H E F A I R ! gomidwest.com Owners: Zach Vick 507-458-6170 Grant Vick 507-429-1585 | Brian Vick Office Number: 507-523-2112 Barn Location: 21241 Dutchman Crossing Rd., Lewiston, MN SALES DAYS: TUESDAYS @ 6PM & THURSDAYS @ 1PM
Bus 507-932-3750 | Fax 507-932-5184 dana@managinginsurance.com Learn more at statefarm.com®
A journey of service, faith

104-year-old WWII veteran recalls fighting days
BY AMY KYLLO STAFF WRITER





BYRON – It is the early 1940s and a transport ship bound for the Western Front of World War II is caught in a typhoon. On board is Marvin Viker, a southeast Minnesota United States Army enlistee.
“The captain, he came down from the ship and told us we were in a pretty bad storm,” Viker said.
Down below, Viker was reading a Gideons International New Testament a friend had.
“I was laying on the top bunk bawling,” he said. “Some of them (soldiers) didn’t know what to do, and they tried to comfort one another.”
His friend with the New Testament asked if Viker was saved spiritually. Not content with Viker’s answers of his church activity, his friend asked him again if he was saved. Part way through the storm, Viker met a turning point in his faith journey.


“I said, ‘Now I see what you’re trying to tell me,’” Viker said.














From that moment on, Viker had one prayer.
“Dear God, I hope it’s in your will that I could go home and see my mama and papa, my brothers and sisters (and friends),” he said. “If not, I’m ready to die for you for my country.”
Viker’s prayer was answered, and at 104 years old, faith radiates from him.
“I was never scared from there on through,” he said.
Viker was born July 22, 1918, and grew up in rural Byron. As a young
man, he worked for the Civilian Conservation Corps in Lanesboro. Viker also received a place to live in addition to the uniform, plenty to eat and candy.

On Nov. 4, 1941, he enlisted in the United States Army, just 37 days before the U.S. declared war on Germany and Japan. He weighed 113 pounds, which was only 3 pounds above the lower limit.
Viker started in California but said he remembers never really undergoing basic training.




After California, Viker was stationed near Seattle, Washington, guarding bombs. Viker said there was a concern that after the attack on Pearl Harbor Dec. 7, 1941, that these bombs would also be in danger.





Viker said they could see Mt. Rainier from where he was stationed. He would walk through the woods on guard duty, two hours on and one hour off. Viker said once he fell asleep at the post and a lieutenant found him. However, the lieutenant had mercy on him, and he was not pun-






ished.
Viker’s tour continued, and he was sent to Tampa, Florida, to learn radar. He said he and his team were tracing airplanes out to 182 miles. He became a head operator, working in a team of three on dish radar that had its own generator.
From there, Viker was shipped overseas on his tumultuous and memorable trip that would change his life forever. The ship made its way through the storm and landed in Africa.
Next on his tour was Naples, Italy.
In Italy, Viker said he remembers buying eggs from a local to eat and taking them back to his tent he shared with seven men.
“I took a helmet, put water in there and cooked the eggs because I just couldn’t stand the C-ration,” he said.


According to the U.S. Army website, soldiers were not supposed to use the helmet over fire, but this rule was often ignored, and soldiers even made coffee in the helmets.

Viker page 15
PHOTOS BY AMY KYLLO
(Above) Marvin Viker, a 104-year-old World War II veteran, stands June 9 on his farm near Byron. Viker was in Italy, the island of Corsica, France and Germany, among other places, during his time of service.






(Above Left Inset) Marvin Viker smiles out of an old military photo June 9 at his home near Byron. Viker enlisted in the U.S. Army Nov. 4, 1941, just 37 days before the U.S. declared war on Germany.
Marvin




Saturday, July 1, 2023 | Country Acres South • Page 13 SOUTH S A SOUT SO H cres C ountry 507-438-7739 julia.m@star-pub.com Olmsted, Filmore & Houston JULIA MULLENBACH Contact us with any story ideas— we’re interested in the people you know and what is happening in your counties and want to tell those stories. 320-260-1248 bob.l@star-pub.com Goodhue & Dodge BOB LEUKAM 320-249-9182 warren@star-pub.com Winona WARREN STONE 320-492-6987 tim.v@star-pub.com Wabasha TIM VOS Reach your customers. Read your country living stories. Sarah Colburn sarah.c@star-pub.com 612-670-2000 Reach over 10,000 homes and businesses in 7 counties. Amy Kyllo amy.k@star-pub.com 507-601-9039
Viker’s back hoe stands June 9 on his farm near Byron. Viker was a partner in Viker and Sorenson Sewer and Water Inc. for 26 years and has personally used his back hoe in the past five to 10 years.
CZJuly1-1B-TV































Page 14 • Country Acres South | Saturday, July 1, 2023 CZJuly1-1B-BL 2840 Wilder Rd. NW Rochester, MN 55901 rochph.com Your local residential and commercial experts since 1922 (507) 288-4275
Jetting clogged or frozen parlor lines • Jetting clogged or frozen pump and gravity manure lines • Vacuuming out large settling tanks • Clearing trench drains • Hydro excavation • Televising of sewer lines We can clean anything from 2” to 60” CZTFN-1B-JM “Your future is secure with us” WWW.PEOPLESSTATEBANK.COM • 800-252-3137 Brian Klavetter Plainview branch CZJuly1-1B-TV CZ_July1-1B-JM Minnesota Farmers have reported savings on the cost of chemicals by using treated water in their sprayers.
SERVICES: •





















































Page 16 • Country Acres South | Saturday, July 1, 2023 www.stjosephequipment.com YOUR LOCAL TRUSTED NEW HOLLAND DEALER FOR OVER 45 YEARS! IN-STOCK DISCOVER WHAT NEW HOLLAND CAN OFFER YOU. EYOTA 507-545-2000 4710 Cty Rd 7 SE • Eyota, MN 55934 LA CROSSE, WI • 608-788-1775 NORWALK, WI • 608-823-7434 RICHLAND CENTER, WI • 608-647-8804 USED EQUIPMENT IN-STOCK #024975 #026188 #025462 #025588 #022529 #026489 #026159 #024634 #026573 499 HAYBINE New Holland 499 Pull Type Haybine, center pivot $3,495 185 MANURE SPREADER Mechanical T-rod apron, hyd. endgate, splash guard, no upper beater $12,900 2018 CR8.90 COMBINE 2 speed powered rear axle, call for more details $299,900 2008 T6030 TRACTOR WITH LOADER with loader $59,900 166 HAY INVERTER New Holland 166 Hay Inverter with extension $3,695 2014 FR600 SELFPROPELLED CHOPPER $189,985 2019 T5.120 TRACTOR Loader, low hours and very clean $84,985 2012 CR8080 COMBINE $125,900 489 HAYBINE $3,495 #024737 #024933 #024126 #024738 #026192 #024744 #024741 #024736 #024746 #024751 #024749 560 ROLL BELT ROUND BALER Specialty crop package, endless belts CALL FOR PRICE 260 PLUS SPEEDROWER with 416 16’ Disc header CALL FOR PRICE FR780 SELFPROPELLED CHOPPER Hay & corn heads available CALL FOR PRICE 460 ROLL BELT ROUND BALER Deluxe wrap, endless belts CALL FOR PRICE 209R DISCBINE 9’2” cutting width, rubber rolls CALL FOR PRICE 107M DISC MOWER 6’8” cutting width, 3 Point hitch mount CALL FOR PRICE FP240 CHOPPER Hay & corn heads available, crop processor CALL FOR PRICE 210R DISCBINE 10’4” cutting width, rubber rolls CALL FOR PRICE 1225 PROCART RAKE CALL FOR PRICE DURA-VEE 1225 RAKE 12 wheel, center kicker wheel CALL FOR PRICE DB313 PLUS DISCBINE 13’1” cutting width, rubber rolls CALL FOR PRICE CZ-July1-1B-JM












 BY AMY KYLLO | STAFF WRITER
BY AMY KYLLO | STAFF WRITER























































































































 Sunshine & Flowers by Amy Kyllo
Sunshine & Flowers by Amy Kyllo














































































 BY AMY KYLLO | STAFF WRITER
BY AMY KYLLO | STAFF WRITER